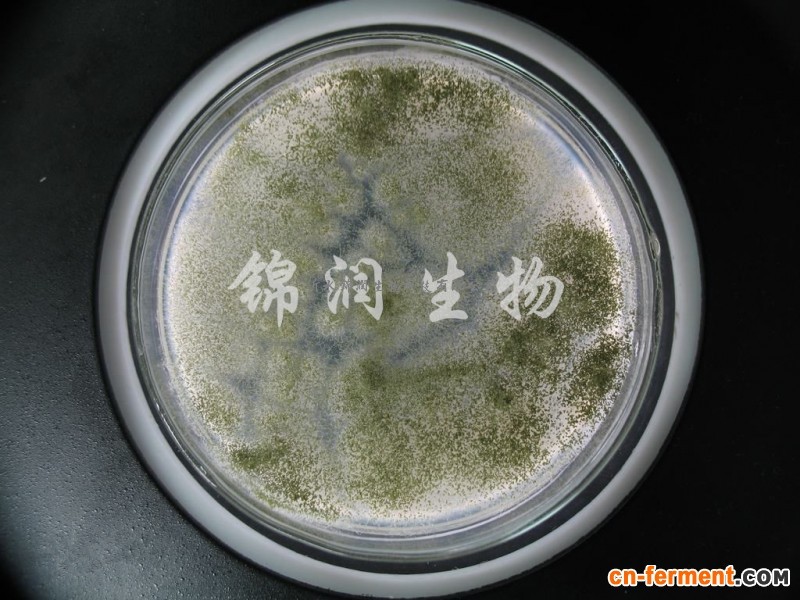

微生物肥
厂家直销米根霉 质量可靠 价格优惠
2019-07-02 14:411579
信息概况
-
价格:¥40.00/kg
-
品牌:锦润
-
活菌数:≥10亿/克
-
水份:≤10%
-
起订:10kg
-
供应:10000kg
-
发货:3天内
联系方式
-
公司:沂水锦润生物科技有限公司
-
姓名:段会文(先生)
-
电话:0539-7128818
-
手机:15854997066
-
地区:山东-临沂市
-
QQ:40769654
同类发酵产品
各地最新发酵项目
-
发酵项目9个月前
-
发酵项目2年前
-
发酵项目3年前
-
发酵项目6年前
-
发酵项目4年前
-
发酵项目4年前
-
发酵项目4年前
-
发酵项目11年前
-
发酵项目4年前
- 查看更多
可租售发酵工厂
-
制药厂2个月前
-
发酵工厂招商11个月前
- 查看更多
寻租赁代加工服务需求
-
求购技术2天前
-
求购技术2天前
-
求购技术1星期前
-
求购技术1星期前
-
求购技术16年前
-
求购技术1星期前
-
求购技术1星期前
-
求购技术1个月前
- 查看更多